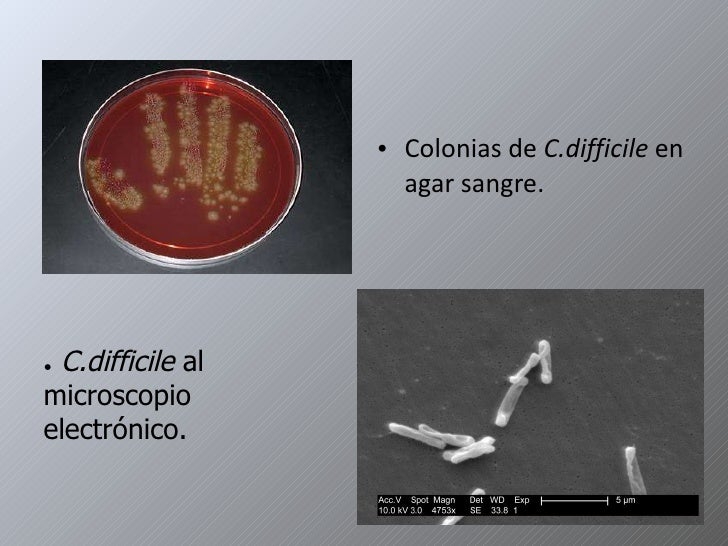

Medication
Recently, the treatment options of CDI have undergone major changes: current recommendations speak against using metronidazole for primary CDI, fidaxomicin and bezlotoxumab have been added to the treatment armamentarium and microbial replacement therapies have emerged. Several other therapies are undergoing clinical trials.
Procedures
· Treatment for recurrent infection Antibiotics. Antibiotic therapy for recurrent infections may involve one or more courses of a medication. The drugs are... Antibody-based therapy. A therapy, known as bezlotoxumab (Zinplava), is a human antibody against the C. difficile toxin... Fecal microbiota ...
Self-care
3 rows · Treatment of Mild-to-Moderate Clostridium difficile–associated Disease. The two most common ...
Nutrition
· Treatment strategies should be based on disease severity, history of prior CDI, and the individual patient’s risk of recurrence. Vancomycin is the treatment of choice for severe or complicated CDI, with or without other adjunctive therapies. Metronidazole is …
What is the best antibiotic for C diff?
Treatment for Clostridium difficile infection depends on your overall health, the severity of the infection and any complications. In most people, home care such as drinking plenty of fluids and eating a bland, starchy diet will help clear up symptoms. Your physician may also recommend:
What is the recovery time for C diff?
determine if treatment is warranted. Treatment of Clostridium difficile colitis For all patients: - Discontinue/change antibiotics if possible. - Avoid PPI/H2 blockers without an appropriate indication. - Implement infection control measures Clinical Setting Initial Episode1,2 First Recurrence1,2,3 Second Recurrence1,3 Non-Fulminant Disease
What is the cure rate for C diff?
· Clostridioides difficile [klos–TRID–e–OY-dees dif–uh–SEEL] is formerly known as Clostridium difficile and often called C. difficile or C. diff.. C. diff is a germ (bacterium) that causes severe diarrhea and colitis (an inflammation of the colon).. Most cases of C. diff infection occur while you’re taking antibiotics or not long after you’ve finished taking antibiotics.
What antibiotics are used to treat C diff?
Commonly prescribed medications include metronidazole, vancomycin, and fidaxomicin. Your doctor chooses the antibiotic based on the severity of your symptoms. For people with a mild-to-moderate C. difficile infection, a doctor may prescribe metronidazole. Those with persistent symptoms or a recurrent C. difficile infection may be given vancomycin.

What is the first line treatment for Clostridium difficile?
difficile are metronidazole (500 mg PO TID) and vancomycin (125 mg PO QID) for 10–14 days. The standard first-line therapy in both the inpatient and outpatient settings remains oral metronidazole, unless there are contraindications to the medicine such as first trimester of pregnancy or inability to tolerate it.
What is the best treatment for Clostridium difficile?
Vancomycin and fidaxomicin are the most effective antibiotics against Clostridium difficile infections. They are both equally effective at wiping out an initial infection. However, patients treated with fidaxomicin have a lower rate of a recurrent C.
What antibiotics treat Clostridium?
Three antibiotics are commonly used for the treatment of CDI: metronidazole (11), vancomycin (12), and fidaxomicin (13). Of these, fidaxomicin and its major active metabolite (OP-1118) have the narrowest reported spectrum of antibacterial activity (14).
How is Clostridium difficile diarrhea treated?
In patients with confirmed C. difficile infection, the offending antibiotic should be withdrawn. The recommended antibiotic is metronidazole (Flagyl) in a dosage of 250 mg orally four times per day or 500 mg orally three times per day for 10 to 14 days.
Does C. diff go away without antibiotics?
For asymptomatic carriers or patients with antibiotic-associated diarrhea, antibiotics to target C. diff aren't needed. “This will usually resolve on its own,” Dr.
Why can't C. diff be treated with antibiotics?
diff produces spores when attacked by antibiotics. The spores can live in the open air or in dirt for up to two years. Normal disinfectants are not effective against the spores. This means that even if you kill the C.
What's the best probiotic for C. diff?
The best studied probiotic agents in CDI are Saccharomyces boulardii, Lactobacillus GG (LGG) and other lactobacilli, and probiotic mixtures.
How long does it take for antibiotics to work for C. diff?
People with Clostridium difficile infections typically recover within two weeks of starting antibiotic treatment.
Is vancomycin better than Flagyl?
Although an early clinical trial found no difference in cure rates between vancomycin hydrochloride and metronidazole,10 subsequent observational data and clinical trials suggest that metronidazole is inferior to vancomycin for primary clinical cure, especially in severe cases.
Which antibiotic causes C. diff?
The primary risk factor for C difficile colitis is previous exposure to antibiotics; the most commonly implicated agents include the cephalosporins (especially second and third generation), the fluoroquinolones, ampicillin/amoxicillin, and clindamycin.
Does metronidazole treat Clostridium?
Clostridium difficile has become the most common cause of healthcare-associated infections in the United States [1]. For >3 decades, metronidazole has been the mainstay of treatment for initial cases of mild to moderate Clostridium difficile infection (CDI) [2].
What is the best treatment for C. difficile?
difficile is another antibiotic. These antibiotics keep C. difficile from growing, which in turn treats diarrhea and other complications. Your doctor may prescribe vancomycin ( Vancocin HCL, Firvanq) or fidaxomicin (Dificid).
What is the procedure to check for C. difficile?
If your doctor is concerned about possible complications of C. difficile, he or she may order an abdominal X-ray or a computerized tomography (CT) scan, which provides images of your colon. The scan can detect the presence of complications such as thickening of the colon wall, expansion of the bowel or, more rarely, a hole (perforation) in the lining of your colon.
What test can detect C difficile toxin B?
Several main types of lab tests exist, and they include: Polymerase chain reaction. This sensitive molecular test can rapidly detect the C. difficile toxin B gene in a stool sample and is highly accurate. GDH/EIA. Some hospitals use a glutamate dehydrogenase (GDH) test in conjunction with an enzyme immunoassay (EIA) test.
What to eat if you have diarrhea?
Other good choices are saltine crackers, bananas, soup and boiled vegetables. If you aren't hungry, you may need a liquid diet at first. After your diarrhea clears up, you may have temporary difficulty digesting milk and milk-based products. By Mayo Clinic Staff. C. difficile infection care at Mayo Clinic.
What age can you take antibiotics for C difficile?
Are older than 65. Are taking other antibiotics for a different condition while being treated with antibiotics for C. difficile infection. Have a severe underlying medical disorder, such as chronic kidney failure, inflammatory bowel disease or chronic liver disease. Treatment for recurrent disease may include:
What type of scan is used to diagnose C. difficile?
If your doctor is concerned about possible complications of C. difficile infection, he or she may order an abdominal X-ray or a computerized tomography (CT) scan , which provides images of your colon. The scan can detect the presence of complications such as:
How to test for C difficile?
This test (flexible sigmoidoscopy or colonoscopy) involves inserting a flexible tube with a small camera on one end into your colon to look for areas of inflammation or abnormal tissue.
What is the best treatment for C. difficile?
The two most common drugs used to treat C. difficileare metronidazole (500 mg PO TID) and vancomycin (125 mg PO QID) for 10–14 days. The standard first-line therapy in both the inpatient and outpatient settings remains oral metronidazole, unless there are contraindications to the medicine such as first trimester of pregnancy or inability to tolerate it. For severe disease, initial therapy with vancomycin is now recommended (Table 1). In all patients with CDAD, inciting antibiotics should be discontinued, if possible, or changed to a regimen with a narrower spectrum. Antimotility agents should not be used, even in mild cases.
What are the symptoms of C. difficile?
Of patients with C. difficileinfection, 3–8% develop fulminant colitis.14Markers of disease severity include ileus, renal insufficiency, colon wall thickening on computed tomography imaging, and endoscopic visualization of pseudomembranes , as well as the usual signs of septic physiology: fever, significant leukocytosis, hypotension requiring fluid resuscitation, and tachypnea. These markers may portend toxic megacolon, imminent intestinal perforation, or fulminant colitis, and they may predict a significantly higher risk of colectomy or death. Empiric therapy should be started for ill patients as soon as C. difficileis suspected, to avoid any delay related to obtaining the results of stool or equivocal examinations. As stool examinations are imperfect, clinical judgment is still vital.
What is the best antibiotic for CDAD?
Several other antibiotics are being studied in the treatment of CDAD. One is nitazoxanide, a nitrothiazolide antibiotic. Musher and associates published a prospective double-blinded study in 2006 comparing metronidazole and nitazoxanide as initial therapy and concluded that nitazoxanide was as effective as metronidazole.25Of note, this initial study excluded ICU patients and those with hemodynamic instability, IBD, advanced liver disease, or renal disease. The same group of researchers recently published an open-label study of nitazoxanide in patients who had failed metronidazole therapy. Twenty-eight patients who had experienced no improvement in symptoms after 14 days of metronidazole (mean duration of treatment, 22.4 days) were prescribed 10 days of 500 mg of nitazoxanide twice daily. Twenty patients (71%) experienced rapid resolution of symptoms, but 6 of these patients later experienced disease recurrence.26Nitazoxanide may have an emerging role in stable patients who do not improve with metronidazole. Although nitazoxanide is relatively expensive, it still costs less than vancomycin; in 2006, the average wholesale price of a 10-day course of nitazoxanide was approximately $240.27
How to diagnose CDAD?
Diagnosis of CDAD is usually confirmed by detection of toxins A and/or B in stools or culture, though the latter does not confirm toxin production . Enzyme immunoassay (EIA) examinations have largely replaced cytotoxin tissue culture assay for toxin B, though their sensitivity and specificity are not as good. False-negative examinations are an important concern for clinicians. Some EIA examinations can detect both toxin A and B; others test only for toxin A and a common clostridial antigen that acts as surrogate marker for the presence of clostridia. As these examinations test for toxin A alone, they do not detect the 2–3% of strains that produce only toxin B. Thus, confirmation for toxin B via examinations such as toxin B assay or polymerase chain reaction is necessary when the EIA for toxin A is negative but the common clostridial antigen is positive. In short, clinical judgment is still very important in diagnosis.
What are modifiable practices that may decrease initial treatment failures?
Modifiable practices that may decrease initial treatment failures include avoiding the use of antimotility agents and discontinuing the causative antibiotic, if possible.
Can you use vancomycin for C difficile?
This trend has increased the emphasis on appropriate treatment regimens in refractory cases of C. difficileinfection. In mild-to-moderate cases, oral metronidazole remains adequate first-line therapy, but in the absence of a good clinical response, switching to vancomycin may be necessary. Oral vancomycin should be used as initial therapy in severely ill patients or patients who cannot tolerate metronidazole. Rectal administration of vancomycin may be used as adjunctive therapy for severely ill patients. Patients with an ileus who cannot tolerate oral medications may improve with adjunct intravenous metronidazole and/or rectal vancomycin. Early surgical consultation should be requested, as some patients will require emergent colectomy. The shifting landscape of C. difficileinfection has undermined our complacency regarding this long-recognized disease.
Is clindamycin a risk factor for C. difficilecolitis?
Cephalosporin and clindamycin usage have long been recognized as risk factors for C. difficilecoli tis, but until recently, fluoroquinolones had not been considered a significant risk. In 2000, Muto and associates noted a spike in fluoroquinolone use in a Pittsburgh hospital that predated the increase of severe CDAD cases by 9 months. A comparison of the 12-month period beginning in March of 1998 with the one beginning in March of 1999 demonstrated that use of fluoroquinolones rose from 217 daily doses to 275 daily doses per 1,000 patient-days.2This coincided with the emergence of a hypervirulent strain, BI/NAP1/027, which had been identified as early as 1984. This strain produces a binary toxin of unknown significance and has an 18 bp deletion in a gene that regulates toxin production. This mutation allows for increased production of toxins A and B in vitro, which may explain why it appears to cause more severe disease. Prior to 2001, BI/NAP1/027 isolates were resistant to clindamycin and levofloxacin (levaquin, Ortho-McNeil). The strain has since acquired resistance to gatifloxacin and moxifloxacin.8In some hospitals, formulary changes to these drugs have predated epidemics.
When did the incidence of Clostridium difficile increase?
Since 2000, the incidence and severity of Clostridium difficileinfection (CDI) have increased.
What are the clinical manifestations of C. difficile infection?
Clinical manifestations of C. difficileinfections (CDI) range from mild diarrhea to life-threatening illness. Prediction rules have been developed to predict recurrences, complications, and mortality40. Many of these studies had small sample sizes, with significant heterogeneity40. One prospective study of 746 patients with CDI proposed the following risk scoring system to predict risk of fulminant CDI: age >70 years (2 points), WBC ≥20,000 cells/mL or ≤2,000/mL (1 point), cardiorespiratory failure (7 points), and diffuse abdominal tenderness (6 points). High risk patients had a score ≥641. Another scoring system study used age, treatment with systemic antibiotics, leukocyte count, albumin, serum creatinine to predict response to vancomycin or fidaxomicin42.
How long does it take to detect C difficile in stool?
difficilein stool is toxigenic culture (TC)(Table 1).19Stool specimens are cultured anaerobically on special media27for 24–48 hours. After colony selection and confirmation of taxonomy (usually with an antigen detection strategy with latex agglutination or enzyme immunoassay (EIA) or real-time PCR),27,28isolates are incubated for 48 hours followed by testing using a cell cytotoxicity assay (CCA)(Table 1). The independent performance of this method is unclear, since most studies compare other diagnostic modalities to TC or CCA,19and there are differences in choice of media and sample pretreatment.
When was Clostridium difficile first identified as the major infectious cause of antibiotic-associated diarrhea?
Clostridium difficilewas first identified as the major infectious cause of antibiotic-associated diarrhea in 19781. However since the emergence of the epidemic BI/NAP1/027 strain of C. difficilein 20002, C. difficileinfections (CDI) have increased in prevalence and become less responsive to treatment2–4.
How to detect toxins in stool?
Filtrates of stool suspensions or culture supernatants are inoculated into a cell culture and assessed for cytopathic effect after 24 or 48 hours.27This test identifies as little as 3 picograms of toxin and is highly sensitive (0.94–1) and specific (0.99), especially if combined with antiserum.27,35The main disadvantage is turnaround time and complexity.
Where is the Division of Infectious Disease and Department of Infection Control located?
1Division of Infectious Disease and Department of Infection Control, St John Hospital and Medical Center, Detroit, Michigan
Does B. difficile produce toxin A?
bC. difficilecan produce toxin A and/or toxin B. Although both play a role in clinical disease , it is not known if strains producing only toxin A are associated with symptomatic infection in humans.
How to treat C diff?
Your physician may also recommend: 1 Stopping antibiotics: In some people, C. diff infection will clear up when antibiotic treatment is suspended. 2 Changing antibiotics: You may need a different type of antibiotic medication, either orally or intravenously, to fight the C. diff infection. 3 Taking probiotics: Taking healthy bacteria and yeast in pill or powder form can help restore the balance of your gut’s microbiome (collection of microorganisms in your digestive tract). 4 Fecal transplant: For people with chronic C. diff infections, transplanting the stool of a healthy person into their colon may help provide long-term protection. 5 Surgery: Removal of the inflamed and damaged portion of the colon may be the only way to stop the infection in some patients.
What is the only way to stop a colon infection?
Surgery: Removal of the inflamed and damaged portion of the colon may be the only way to stop the infection in some patients.
Can you change antibiotics for C diff?
Changing antibiotics: You may need a different type of antibiotic medication, either orally or intravenously, to fight the C. diff infection.
What is C diff?
C. diff is a germ (bacterium) that causes severe diarrhea and colitis (an inflammation of the colon). Most cases of C. diff infection occur while you’re taking antibiotics or not long after you’ve finished taking antibiotics. C. diff can be life-threatening. What is C. diff?
Can you get C diff while on antibiotics?
Most cases of C. diff infection occur while you’re taking antibiotics or not long after you’ve finished taking antibiotics.
How long does it take for C. difficile to return?
C. difficile returns in about 20 percent of people treated with antibiotics because the initial infection never went away or the person was reinfected with a different strain of the bacterium. Symptoms such as diarrhea typically appear three days to three weeks after treatment is discontinued.
What are the side effects of C. difficile?
Side effects of these medications include nausea, a bitter taste in the mouth, and abdominal pain. C. difficile returns in about 20 percent of people treated with antibiotics because the initial infection never went away or the person was reinfected with a different strain of the bacterium.
What antibiotics can you take for diarrhea?
Commonly prescribed medications include metronidazole, vancomycin, and fidaxomicin. Your doctor chooses the antibiotic based on the severity of your symptoms.
Can you stop antibiotics for diarrhea?
For people with mild antibiotic-associated diarrhea and no fever or abdominal pain, stopping antibiotics may be the only treatment necessary. If discontinuing the antibiotics does not alleviate your symptoms, your doctor recommends another antibiotic to eliminate the original infection, as well as the diarrhea.
Does Clostridium difficile kill all bacteria?
It is important to continue taking the medication until you finish it. Otherwise, it may not kill all of the C. difficile bacteria and may lead to a recurrence. Clostridium Difficile Infections in Adults. Find a Doctor & Schedule. Prevention. Diagnosis. Medication. Fecal Microbiota Transplantation. Recovery & Support.
Can you stop antibiotics for Clostridium difficile?
Medication for Clostridium Difficile Infections. If you are taking antibiotics and have an infection with Clostridium difficile, your NYU Langone doctor discontinues the medication that triggered the infection, if possible. For people with mild antibiotic-associated diarrhea and no fever or abdominal pain, stopping antibiotics may be ...
What is C diff?
C. diff is a spore-forming, Gram-positive anaerobic bacillus that produces two exotoxins: toxin A and toxin B. It is a common. cause of antibiotic-associated diarrhea (AAD). It accounts for 15 to 25% of all episodes of AAD.
How long does it take for C diff to be undetectable?
C. diff toxin is very unstable. The toxin degrades at room temperature and might be undetectable within two hours after collection of a stool specimen. False-negative results occur when specimens are not promptly tested or kept refrigerated until testing can be done.
What is a PCR test for C diff?
Molecular tests: FDA-approved PCR assays, which test for the gene encoding toxin B, are same-day tests that are highly sensitive and specific for the presence of a toxin-producing C. diff organism. Molecular assays can be positive for C. diff in individuals who are asymptomatic.
How long does it take for a CDI to resolve?
Although in about 20% of patients, CDI will resolve within two to three days of discontinuing the antibiotic to which the patient was previously exposed, CDI should usually be treated with an appropriate course (about 10 days) of treatment, including oral vancomycin or fidaxomicin. After treatment, repeat C. diff testing is not recommended if the patient’s symptoms have resolved, as patients often remain colonized.
What surface is contaminated with feces?
Any surface, device, or material (such as commodes, bathtubs, and electronic rectal thermometers) that becomes contaminated with feces could serve as a reservoir for the C. diff spores.
How to prevent CDI?
CDI can be prevented by using antibiotics appropriately and implementing infection control recommendations to prevent transmission.
Is colonization more common than CDI?
Colonization is more common than CDI. The patient exhibits NO clinical symptoms (asymptomatic) but does test positive for the C. diff organism or its toxin.With infection, the patient exhibits clinical symptoms and tests positive for the C. diff organism or its toxin. Top of Page.